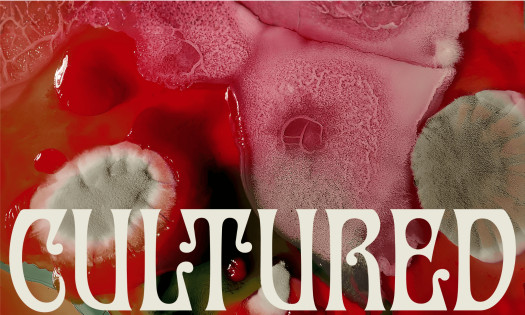
Close-up of organic mold textures in red and pink tones forming abstract patterns, used as part of the OFFF Barcelona "Cultured" campaign visual identity by Uncommon Creative Studio.

Receive our NewsletterJoin over 70,000 B2B decision-makers growing their brands
Trending Brand News - offf barcelona
OFFF Barcelona Turns Community Bio Traces Into ‘Cultured’ Identity
| 4 hours ago | 3 min read
Receive our NewsletterJoin over 70,000 B2B decision-makers growing their brands